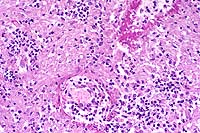

Signalment: Two horses: One 16-year-old male Holsteiner; one 5-year-old male miniature horse.
History: Both stallions presented within a two-month period. The first horse developed renal dysfunction. On ultrasound examination, there was a 15cm diameter mass involving the right kidney. The animal subsequently developed bilateral optic neuritis. His condition progressed to seizures and coma. This animal was euthanized. The second horse had a six-week long illness characterized by significant testicular enlargement and uveitis. This animal developed ataxia and died.
Halicephalobus (Micronema) deletrix has been sporadically associated with equine infections. Vulnerable organs include brain and spinal cord, optic nerve, lungs, skin, kidneys, maxilla, nasal cavities, bone and joints, and testicles. The organism has been reported in human infections and has also been seen causing extensive encephalitis in a big horn sheep in this laboratory.
Halicephalobus is an interesting parasite in that, to date, only females have been identified. This Order of nematode (Rhabditida) can be found free-living in soil and humus. No free-living Halicephalobus has yet to be found. Infections have been postulated to be associated with skin wounds. Of interest here is that viable organisms were noted in the sperm and urine of both stallions, suggesting the possibility of a urogenital route of infection.


Conference Note: Halicephalobus infection has been reported in Japan, Egypt, Switzerland, the Netherlands, the United Kingdom, Colombia, and the United States. Inflammation of the central nervous system is a consistent feature of infection in human beings and almost always occurs in equine infections. The brain is the most commonly involved tissue, followed in descending order by the kidneys, oral and nasal tissues, lymph nodes, lungs, spinal cord, and adrenal gland. There are also reports of involvement in the heart, liver, stomach, ganglion, bone, and prepuce. (Dunn DG, et al, 1993).
The genus Halicephalobus is in the order Rhabditida. There are eight members of the genus, all of which are free-living saprophytes found in soil and decaying organic matter, except for H. deletrix. No free-living form of the nematode has been found, and only females of the species have been identified.
Other rhabditid parasites infecting the horse include Pelodera strongyloides, Strongyloides westerii and Cephalobus sp. These nematodes must be differentiated from H. deletrix in verminous cutaneous or mucocutaneous lesions. Differentiation is based upon location and severity of lesions and parasite morphology. Pelodera causes a self-limiting dermatitis normally confined to the ventral abdomen and limbs. The life-cycle of Strongyloides westerii involves cutaneous penetration by larvae; adults and eggs are not found in the skin. Cephalobus sp. can be distinguished from H. deletrix by its blunt posterior end and differences in the shape of the stoma and esophagus (Cephalobus has a greater ratio of corpus to isthmus).
In North America, other causes of equine verminous encephalitis may include Hypoderma bovis, Hypoderma lineatum, Strongylus vulgaris, and Draschia megastoma. Setaria spp. are reported to be a common cause of cerebrospinal nematodiasis in horses in Asia. Other causes of ataxia in horses include trauma, degenerative myelopathy, Wobbler's syndrome, neoplasia, and various infectious agents.
The pathogenesis, life-cycle, and route of infection of H. deletrix are poorly understood. The route of infection in humans seems to be from manure contaminated skin lacerations. Speculated routes of infection in the horse include: skin and mucous membrane penetration in recumbent animals by the free-living form of the parasite in the soil with subsequent invasion of the sinuses and bones of the head, and/or hematogenous spread to internal parenchymal tissues; prenatal or transmammary infection of suckling foals (there are reports of mammary gland infection with facultative rhabditid nematodes) (Buergelt CD, 1991). The two cases presented here are of interest for two reasons in particular: these are the first cases in which H. deletrix was identified in urine or sperm; these two horses were located geographically near each other, and both died within a two-month time frame. While more research is needed, the potential for a urinary or reproductive route of infection may also exist.
Signalment: Canine, Rottweiler, female, 4-year-old.
History: The dog resided in St. Thomas, Virgin Islands. The animal was examined for chronic bloody diarrhea which did not respond to antibiotics. Fecal examination was negative. Tissue samples of the descending colon were collected during exploratory celiotomy.
Gross Pathology: A full-thickness biopsy of the descending colon was submitted. The wall of the colonic segment was thickened and firm.
Laboratory Results: None.
Contributor's Diagnoses and Comments: Colitis, eosinophilic,
granulomatous, diffuse, severe with hyphae (Pythium spp.)
The submucosa is effaced and expanded by a nodular to diffuse
granulomatous infiltrate which occasionally extends into the overlying
lamina propria. Infiltrates are predominantly composed of neutrophils,
eosinophils, macrophages, and rare multinucleate giant cells.
The mucosa is frequently ulcerated with associated hemorrhage
and congestion. Within the centers of granulomatous foci, there
are small amounts of granular eosinophilic material (Splendore-
Hoeppli reaction) which is closely associated with poorly stained
hyphae. Examination of Grocott's methenamine silver-stained sections
identifies branching, rarely septate hyphae, 5-10 microns in diameter
with coarse, nearly parallel walls within the centers of granulomas.
A presumptive diagnosis of gastrointestinal pythiosis was based
on histologic findings. Diagnosis was confirmed by immunohistochemistry
kindly performed at the Louisiana State Diagnostic Laboratory.
Canine gastrointestinal pythiosis is characterized by severe granulomatous inflammation of the gastrointestinal tract and associated tissues. The disease is caused by Pythium insidiosum, an aquatic oomycete of the Kingdom Protista. The organism is found in tropical and subtropical climates, with most case reports in the United States limited to states bordering the Gulf of Mexico. Clinical histories associated with the disease include anorexia, weight loss, vomiting, and diarrhea. The stomach and small intestine are the most frequently recorded locations of the lesion, although any region of the alimentary tract can be affected. Involvement of the mesentery, mesenteric lymph nodes, and pancreas has also been noted. Definitive diagnosis is based on morphologic findings combined with culture and/or immunohistochemisty.


Conference Note: Many different species of Pythium exist, and they are ubiquitous in soil and aquatic environments. Several are important plant pathogens. In animals, pythiosis is an invasive, pyogranulomatous disease caused by the aquatic pathogen, Pythium insidiosum. This water mold is a member of the protoctistid class Oomycetes. The organism causes cutaneous, gastrointestinal, or multisystemic disease in dogs, cats, horses, cattle, and people worldwide in wet, tropical, and subtropical climates. In chronic infections, the organism may invade bone, lung, and other organs. The disease was first recognized in horses and has been known by several synonyms in this species including: bausette, bursattee, Florida horse leeches, kunkers, and swamp cancer. The dog and horse are most commonly affected.
Water molds differ from true fungi in several ways: they produce
motile, flagellate zoospores; have cell walls with cellulose and
beta-glucan but without chitin; and have fundamentally different
nuclear division and mitochondrial and Golgi structures. The infective
stage is the biflagellate aquatic zoospore. Zoospore release is
seasonal and associated with warm weather. Water lilies and other
aquatic plants and submerged grasses, including rice plants, are
thought to be normal hosts.
While the pathogenesis of P. insidiosum infection is not entirely
understood, some mechanisms of disease have been proposed and
demonstrated in vitro. Apparently, the organisms develop zoospores
on the surface or within lily-pad leaves and on several other
plant species. The zoospores move through water toward damaged
plant or animal tissues. Once in the vicinity of the "presumed"
attractants, the zoospores become sluggish, lose their flagella,
assume a rounded form, and become encysted on tissue. The organisms
have a strong tropism for horse skin and hair, human hair, and
water-lily and grass leaves. After encystment, the zoospores develop
germ tubes in the direction of the affected tissue; these germ
tubes allow for penetration and invasion into tissue. Most animals
infected with P. insidiosum have a history of close contact with
wet, swampy environments or stagnant water. Motile zoospores are
released into these environments during warm months and infect
the animal when they contact damaged skin or are ingested.
Because the plasma membranes of Pythium spp. lack sterols such as ergosterol, the target of action of the azole fungicides, chemotherapy alone has not been successful in treatment of the disease. Thus, the prognosis in the patient with pythiosis is poor unless the affected tissue can be completely excised. Wide surgical excision is the only effective treatment, and even when accomplished, a guarded prognosis is warranted due to the unpredictable nature of the organism. Examples of wide surgical excision include limb amputation and removal of gastrointestinal lesions that are considered resectable. Histopathological examination of regional lymph nodes and of arteries from the proximal end of the amputated limb is indicated to assess whether the infection has spread systemically.
Pythiosis is extremely rare in cats but may carry a slightly better prognosis because of a difference in biological behavior. Although pythiosis tends to be a rapidly progressive, ulcerative disease with draining tracts in most other affected species, cats often have only mild clinical signs with no draining tracts, and the disease progresses slowly. Although effective oral ketoconazole therapy is described in a cat diagnosed with nasal pythiosis, surgical excision remains the treatment of choice in infected cats.
Although Pythium insidiosum is a pathogen of humans and animals, its zoonotic potential is believed to be low because the infective form (the zoospore) is not known to form in tissue. Microbiologists attempting to induce zoospore development must use extreme caution.
Contributor: University of Connecticut, Department of Pathobiology U-89, 61 North Eagleville Road, Storrs, CT 06269-3089
International Veterinary Pathology Slide Bank:
Laser disc frame #3763-3765; 3366.
Signalment: Salt water, penned Atlantic salmon (Salmo salar), first and second year class stock; average weight is 2.45 kg.
History: Over the course of several months, approximately 6-16% of the stock of 100,000 fish developed lenticular cataracts. The fish were intensively farmed and maintained on a low grade, producer formulated ration. The overall lesion prevalence at the time of harvest was between 6-16% and varied according to weight class.
Gross Pathology: Gross examination disclosed unilateral and asymmetric, lenticular opacity. At slaughter, there was moderate variation in fish size with smaller fish exhibiting a greater prevalence of cataracts relative to larger stock.
Laboratory Results: None.
Contributor's Diagnosis and Comments: Eye, lens: Cataracts, moderate to moderately severe, subacute to chronic. Etiology: Presumptive nutritionally induced cataract.
Eye, composite description: Within multiple lenses, there is focal to segmental, subcapsular, laminar fragmentation and liquefaction of the fibers and replacement by variably sized, irregular, coalescing, vacuoles which contain finely granular to globular, eosinophilic deposits. In more severely affected eyes, virtually the entire lens is affected with clefts and protein lakes dispersed throughout the fibers. In multiple lenses, there are solitary to confluent bladder cells. Immediately below the capsule in approximately half the fish, there is focal to focally extensive epithelial degeneration and necrosis with attendant hyperplasia and rare, fibrous metaplasia.


Conference Note: This case was studied in consultation with the Department of Ophthalmic Pathology. Some participants noted small amounts of a laminar, hypereosinophilic, vacuolated, material within the cornea just anterior to Descemet's membrane. This finding is interpreted as accumulation of a proteinaceous material. Its significance is unknown.
The lens of salmonids is a spherical ball consisting of three tissues. One is an encapsulating sheath of noncellular transparent material, which is secreted by the second tissue, the underlying layer of physiologically active cells. The cells are nucleated and are capable of division and secretion. The third tissue, immediately beneath these active cells, and by far the greatest in volume, consists of the lens fibers. These fibers are long, slender, transparent, non-nucleated cells lying in layers of long parallel rows. Each layer is one cell thick and is loosely cemented to the layer above and below it. While the mammalian lens is elastic and can be modified in shape by contraction of the eye muscles, the fish lens is inelastic and must be drawn inward toward the retina by the retractor lentis muscle to accommodate changing sight requirements.
Because of its simple structure, physiology, and lack of vascularity, the morphologic changes that the lens can exhibit are primarily limited to: abnormal growth changes in the epithelium (epithelial hyperplasia and metaplasia); deterioration of the lens protein with coagulation and disorganization of the lens fibers (hydropic change; deposition of calcium salts or cholesterol); and rupture of the capsule which exposes the lens substance to external forces that may lead to liquefaction, organization, or dissolution. The precise mode of action of substances harmful to the lens is not always clear, but changes in the aqueous, which bathes and provides nutrition to the lens, probably precede any effects.
Cataract is the most common and most important disorder of the lens. A cataract is a lenticular opacity due to disruption of the lamellar structure of lens fibers and is a nonspecific change that may have various etiologies. They may be classified on the basis of morphologic appearance, etiology, location, maturity, and extent. The principal locations of cataracts include the subcapsular epithelium, the cortex, and the nucleus of the lens.
Subcapsular cataracts occurring under the anterior capsule (anterior polar cataract) are the result of abnormal proliferation of the lens epithelium at this site, and histologically the change is termed epithelial hyperplasia or fibrous metaplasia. The lesion often results from traumatic injury to the lens capsule, or adherence of the iris or of persistent pupillary membranes to the anterior surface of the lens. Each redundant epithelial layer, even if disorganized and metaplastic, secretes a new basement membrane that separates each layer from adjacent layers. The end result is a focal plaque formed by multiple sandwiched layers of flattened epithelium and basement membrane.
Traumatic injury to the lens may present with a different histologic appearance when the lens capsule is ruptured, though the lesion is still primarily subcapsular. Rupture of the capsule allows for massive release of native lens protein and may cause a severe perilenticular nonsuppurative endophthalmitis. The capsular rent also permits leukocytes to enter the lens and speeds dissolution of the lens fibers. Subsequent fibroblastic metaplasia of the lens epithelium may result in cartilage or even bone formation within the lens. Lens trauma may result from a severe blow to the head or penetrating wounds to the eye.
Posterior polar cataract, located under the capsule at the posterior face of the lens, also results from abnormal growth of the lens epithelium. However, absence of nucleated epithelium on the posterior surface in the normal adult mammalian eye indicates that epithelial cells must grow and migrate into this area from the equator to form a cataract. This reestablishment of fetal morphology is seen most commonly with any chronic cataract in young animals, whose epithelial cells are thought to retain greater migratory ability. Damage to the lens capsule at this site often results in degeneration of the lens fibers at this site and within adjacent cortical fibers. Following damage to either the anterior or posterior aspect of the lens, water may enter the lesion further contributing to opacity (intumescent cataract).
Cortical cataracts result from disorganization of the lens fibers usually as a result of altered metabolism of the lens epithelium. Lens fibers become degenerate, lose their normal concentrically laminated structure, and break into pieces that rapidly contract to acquire rounded ends. In contrast, artifactually shattered fibers have sharp, jagged ends. As fiber fragmentation progresses, the fragments liquefy, assume a spherical shape, and are referred to as morgagnian globules. Clefts and protein lakes appear between fibers, presumably as the result of complete liquefaction of fibers. Abortive efforts at new fiber formation by lens epithelium results in the formation of large, foamy nucleated cells called bladder cells, pathognomonic of cataract.
Nuclear cataracts are the result of changes in the transparency of the oldest lens fibers (those in the nucleus). These central fibers become more dense and appear gray or yellowish in the center of the lens. This type of cataract appears more often in senile animals.
In addition to direct trauma, cataracts may result from exposure
of the lens to a wide variety of insults including toxins, infectious
agents, nutritional excesses and deficiencies, nearby inflammation,
cold, solar and other irradiation, increased intraocular pressure,
and congenital defects. Congenital cataracts often represent a
defect in closure of the primary lens vesicle; this results in
lesions near the lens periphery toward the posterior lens surface.
Viral infections in utero or early in life may cause cataracts;
rubella in humans and herpesvirus infection in dogs provide examples.
Diabetic cataract is a classic example of metabolically induced
cataract formation. Disophenol, an anthelmintic, and dimethyl
sulfoxide can cause cataracts in dogs, and oxygen toxicity may
lead to cataracts in mice. The common denominator in the pathogenesis
of most causes of cataract is the ability to upset the balance
of substrate supply and enzymic activity within the anaerobic
environment of the lens. This imbalance results in the degeneration
of fibers, accumulation of nonmetabolized substrate, or production
of abnormal metabolites. Excess substrates and/or abnormal metabolites
are osmotically active and serve to draw water into the normally
dehydrated environment of the lens causing opacity.
Contributor: Animal Health Centre, 1767 Angus Campbell Road, Abbotsford,
BC, V3G 2M3, CANADA
Signalment: Nine-year-old, male, Chow Chow dog, Canis familiaris.
History: A one-month duration of weight loss was reported. Three days prior to euthanasia, the dog developed episodic blindness, pacing, head pressing, seizures, lethargy, and high fever (106 F).
Gross Pathology: The retropharyngeal, pulmonary hilar, mesenteric, and popliteal lymph nodes were enlarged and mottled red and white on both capsular and cut surfaces. Splenomegaly and multifocal gastric ulcers were present. The kidneys were mildly swollen and reddened on the cut surface. The central nervous system had no gross lesions.
Laboratory Results: Rickettsia rickettsii organisms were detected in the brain by direct immunofluorescence. Gram's, acid fast, PAS, and GMS stains were negative. Hematologic examination revealed a combination inflammatory and stress leukogram with a left shift (700 bands) and a lymphopenia.
Contributor's Diagnosis and Comments: Brain: Severe, subacute, multifocal to coalescing, neutrophilic choriomeningoencephalitis with necrotizing vasculitis. Etiologic Agent: Rickettsia rickettsii, Rocky Mountain spotted fever (RMSF).
This slide demonstrates the characteristic features of RMSF. There is a necrotizing vasculitis with endothelial cell hypertrophy and a widespread perivascular and vascular infiltrate composed of neutrophils, macrophages, and lymphocytes. The vascular lesion is well demonstrated in the choroid plexus. Areas of malacia with gitter cells and large numbers of neutrophils are present.
In addition to the brain, a similar necrotizing vasculitis was found in other sites including the lymph nodes, lung and colon. Perivascular regions were infiltrated with a population of inflammatory cells similar to those in the brain. Lymph node edema was prominent.

Conference Note: Due to section variability, not all slides have examples of fibrinoid change in vessels. When present, vascular walls of small vessels are hyalinized with loss of the endothelium. Most sections demonstrate some necrosis of vessels.
Rickettsiae predominately infect host endothelial and vascular smooth muscle cells, causing a widespread vasculitis of many organs that may be complicated by thrombosis and hemorrhages. Organs with endarterial circulation, such as the skin, brain, heart, and kidneys are frequently affected.
Rickettsiae rickettsii enters the body through the bite of infected ticks. The organisms are disseminated via the circulatory system and invade the endothelium of smaller arteries and venules by binding to cholesterol-containing receptors, allowing endocytosis into phagolysosomes. The rickettsia then escape into the cytosol and multiply until the endothelial cells burst. Phospholipase and proteases have also been incriminated as mechanisms for rickettsial damage to cell membranes. Rickettsiae also produce an endotoxin but lack exotoxins.
Endothelial cell damage initiates vasculitis with platelet activation and activation of the coagulation system accompanied by decreased plasma levels of antithrombin III and plasminogen and increased fibrinogen degradation products. Progressive necrotizing vasculitis may be caused sequentially by complement activation, followed by cellular chemotaxis in which vessels are infiltrated by neutrophils and mononuclear cells. Additionally, Rickettsia rickettsii activate host kallikrein and kinins and so cause local clotting. The effects of Rickettsia rickettsii on endothelial cells account for the vascular necrosis, thrombosis, and subsequent microinfarcts seen microscopically.
The earliest and most consistent clinical finding is fever, which usually occurs within 2 to 3 days after tick attachment. The incubation period ranges between 2-14 days. Acute cutaneous lesions in dogs include edema and hyperemia of the lips, penile sheath, scrotum, pinna, and rarely the ventral abdomen. Clear vesicles and focal erythematous macules may be found on the buccal mucosa. Petechial and ecchymotic hemorrhages may develop subsequent to the acute illness, and if present, usually occur on ocular, oral, and genital mucous membranes rather than on the skin. Humans with glucose-6-phosphate dehydrogenase deficiency and English Springer Spaniels with suspected phosphofructokinase deficiency have a more fulminant course of illness and are more likely to develop dermal necrosis. Epistaxis, melena, and hematuria may be noted in severely affected animals. Clinical signs of both generalized central nervous system involvement or focal localized neurologic signs, such as vestibular disease, are common. Generalized lymphadenopathy and splenomegaly are usually found. Central nervous system signs and death may relate to cardiorespiratory depression induced by edema of the medullary centers. Acute renal failure, a fatal complication of RMSF in people, is infrequently reported in dogs.
As a result of vascular injury and vasculitis, thrombocytopenia is one of the most consistent hematological abnormalities in infected dogs. Platelet counts generally range from 23,000 to 220,000 per microliter. Megathrombocytosis is usually detectable in a majority of cases. A mild prolongation of the Activated Coagulation Time (ACT) may be the only coagulation abnormality. Rarely, disseminated intravascular coagulation (DIC) may occur in dogs and is characterized by prolongation of the ACT, prothrombin time (PT), activated partial thromboplastin time (APTT), and thrombin time with elevated fibrin degradation products (FDP's).
Dogs are a potential source for human infection because they carry infected ticks into nonendemic areas or into closer proximity with people. Humans may then be exposed by transfer of unattached ticks from dogs to themselves or by contact with the engorged tick's hemolymph during tick removal or by contact with tick excreta with the person's abraded skin or conjunctivae. The clinical manifestations in affected people closely parallel those signs seen in dogs. Headache and fever are the most consistent manifestations of disease in people. Death is more of a problem in people who develop severe hepatomegaly, jaundice, stupor, and azotemia. Meningoencephalitis, myocarditis with cardiac arrhythmias, and DIC are often present in terminal human patients.
Contributor: Colorado State University, College of Veterinary Medicine and Biomedical Sciences, Department of Pathology, Fort Collins, CO 80523-1671
International Veterinary Pathology Slide Bank:
Laser disc frame #24686
Ed Stevens, DVM
Captain, VC, USA
Registry of Veterinary Pathology*
Department of Veterinary Pathology
Armed Forces Institute of Pathology
(202)782-2615; DSN: 662-2615
Internet: STEVENSE@afip.osd.mil
* The American Veterinary Medical Association and the American College of Veterinary Pathologists are co-sponsors of the Registry of Veterinary Pathology. The C.L. Davis Foundation also provides substantial support for the Registry.